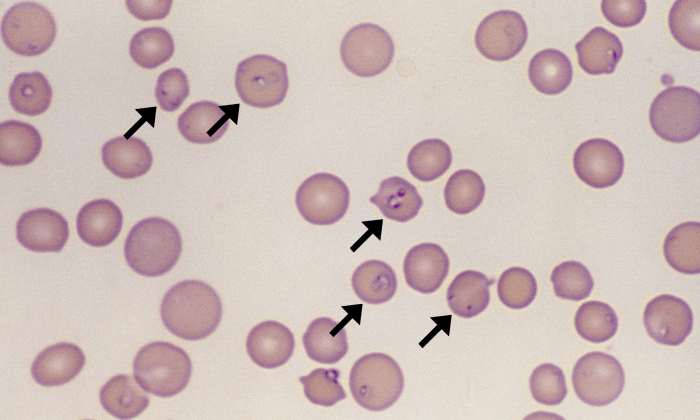
Cytauxzoon felis 1 ARROWS

Cytauxzoon felis
Morphology: small ring-shaped piroplasms with a dark eccentric nucleus inside red blood cells. Usually 1 – 2 piroplasms per red cell.
Look alikes: siderocytes, Howell-jolly bodies, Babesia felis
Commonly seen with: Mycoplasma haemofelis (concurrent infection)
Clinical relevance: Cytauxzoon felis is a protozoal parasite that infects cats. Causes severe (often fatal) disease with non-specific clinical signs; pancytopenia and coagulopathy are common; post-mortem findings include hemorrhage, edema, and thrombosis.

